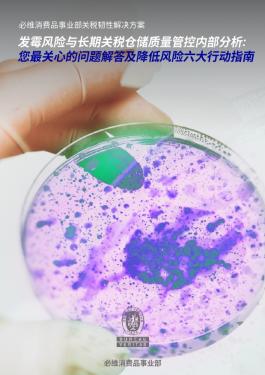
霉风险与长期关税仓储质量管控内部分析: 您最关心的问题解答及降低风险六大行动指南

必维关税韧性计划
在不断变化的全球环境中保护您的供应链
与必维这一值得信赖的供应链和采购合作伙伴携手,共同应对关税波动,推进供应链多样化,进而降低成本、提高质量并确保利润。
全球贸易格局已进入一个充满变数的波动期,其驱动因素是不断攀升的关税地缘政治紧张局势和供应链中断。对于采购主管和首席执行官们一样,使生产多样化的必要性从没有像现在这样紧迫,或者说更加复杂。作为值得信赖的供应链和采购合作伙伴,我们可以帮助决策者在不确定的时代建立有韧性、具有成本效益的供应链。
挑战:为何缺乏灵活性的采购模式无法应对当今全球供应链
全球供应链正在经历一个动荡的局面,在地缘政治变化、关税压力和运营惯性的重压下,传统的采购战略正在崩溃。以下是我们的研究和客户的一些关键采购趋势和见解,说明了非敏捷方法为何步履蹒跚:
1.多元化势在必行
· 75%的玩具/青少年产品和61%的小家电仍然依赖中国,使企业面临关税冲击。
· 越南(33%的鞋类生产)和柬埔寨(15%的行李/包)等新兴市场增长迅速,但失败率比成熟市场高出两倍以上。
2.转移生产的隐性成本
· 当地知识差距:语言障碍、文化不匹配和不熟悉的法律框架延迟了与供应商的合作。
· 质量不一致:印度和印度尼西亚的工厂在服装方面的质量表现比中国差50%以上,而墨西哥的表现比中国强50%。
· 产能限制:中国1%的产量相当于SEA产量的10%,新地区的规模需要精确。
3.关税驱动的利润侵蚀
· 关税增加使家具(+2%)和食品接触产品(+8%)等类别的供应链成本同比增加6-10%。如果不采取干预措施,这些成本就会蔓延到消费者身上,或压缩利润。
以下是突出当前供应链多元化趋势和相关风险的其他见解:
关键洞察力:多元化正在加速,但成功与否取决于能否在新市场上降低质量、容量和合规风险。
与必维合作打造更具韧性的供应链
我们致力于成为您值得信赖的供应链和采购合作伙伴,帮助您驾驭当今动荡的全球市场,建立持久的韧性。我们的专业知识和创新解决方案旨在降低风险,提高质量,并提高整个运营的效率。
让我们共同努力,为您的供应链创造未来,为您开启新的增长机会。